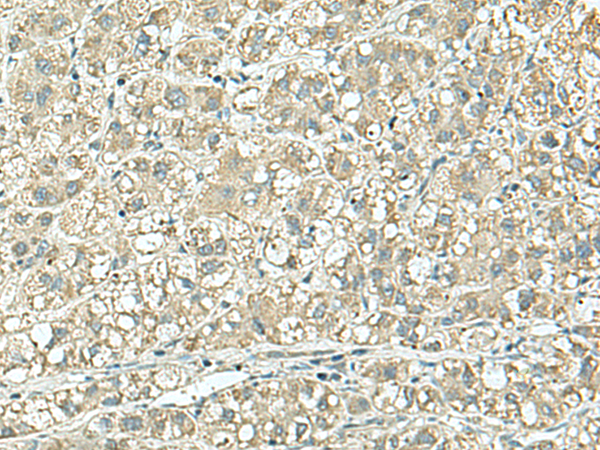

中文名稱:兔抗CD9多克隆抗體
英文名稱: Anti-CD9 rabbit polyclonal antibody
別 名: CD9 molecule; MIC3; MRP-1; BTCC-1; DRAP-27; TSPAN29; TSPAN-29
相關(guān)類別: 一抗
儲(chǔ) 存: 冷凍(-20℃)
宿 主: Rabbit
抗 原: CD9
反應(yīng)種屬: Human, Mouse, Rat
標(biāo) 記 物: Unconjugate
克隆類型: rabbit polyclonal
技術(shù)規(guī)格
|
Background: |
This gene encodes a member of the transmembrane 4 superfamily, also known as the tetraspanin family. Tetraspanins are cell surface glycoproteins with four transmembrane domains that form multimeric complexes with other cell surface proteins. The encoded protein functions in many cellular processes including differentiation, adhesion, and signal transduction, and expression of this gene plays a critical role in the suppression of cancer cell motility and metastasis. |
|
Applications: |
ELISA, WB, IHC |
|
Name of antibody: |
CD9 |
|
Immunogen: |
Synthetic peptide of human CD9 |
|
Full name: |
CD9 molecule |
|
Synonyms: |
MIC3; MRP-1; BTCC-1; DRAP-27; TSPAN29; TSPAN-29 |
|
SwissProt: |
P21926 |
|
ELISA Recommended dilution: |
5000-10000 |
|
IHC positive control: |
Human liver cancer |
|
IHC Recommend dilution: |
25-100 |
|
WB Predicted band size: |
25 kDa |
|
WB Positive control: |
Mouse lung tissue lysate |
|
WB Recommended dilution: |
500-2000 |
購(gòu)物車
幫助
021-54845833/15800441009
